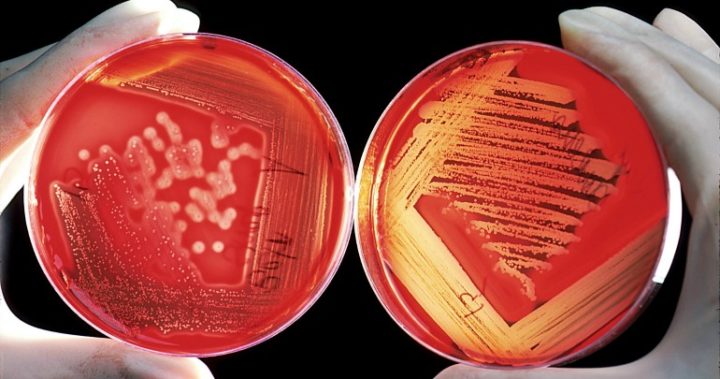

Horrific cases of flesh-eating ulcers are on the increase in Australia, with health professionals warning that more needs to be done to curb the epidemic.
Known as buruli ulcers, the condition is caused by an aggressive bacteria called myobacterim ulcerans that eats away the flesh, causing painful and unsightly ulcers full of pus to form all over the body.
Buruli ulcers are of particular concern in regional Victoria, where cases have increased by 51 per cent in a single year. In 2016, 156 people were diagnosed with the condition, but that number jumped to 236 in 2017. What makes it worrying is that although the medical profession has known of the existence of buruli ulcers since 1948, it’s not yet known how humans contract them.
The rapid rise in case numbers has been highlighted in the Medical Journal of Australia, where author Daniel O’Brien said the ulcers were becoming increasingly aggressive in recognised cases, and appearing in new areas of the country.
“[In Victoria], the community is facing a worsening epidemic, defined by cases rapidly increasing in number, becoming more severe in nature, and occurring in new geographic areas,” O’Brien said in a statement. “In 2016, there were 182 new cases — the highest ever reported by 72 per cent. Yet, cases reported until 11 November 2017 have further increased by 51% compared with the same period in 2016.”
O’Brien said it was difficult to treat or prevent the condition when information about it was so scarce, although it has also been seen in Queensland, New South Wales, the Northern Territory and Western Australia.
“Despite being recognised in Victoria since 1948, efforts to control the disease have been severely hampered because the environmental reservoir and mode of transmission to humans remain unknown,” O’Brien explained. “It is difficult to prevent a disease when it is not known how infection is acquired.”
In most cases, the bacteria is associated with contact with wetlands, particularly those with still or slow-flowing waters. While nothing is confirmed, many scientific theories point out that it could be transmitted to humans through mosquitoes, biting aquatic insects and even possum faeces. O’Brien also noted that the cases appeared to be worse in the summer months.
Read more: The cures and causes of painful mouth ulcers
“The risk of infection appears to be seasonal, with an increased risk in the warmer months,” O’Brien and his research colleagues said. “Lesions most commonly occur on exposed body areas, suggesting that bites, environmental contamination or trauma may play a role in infection, and that clothing may protect against disease.”
He added that it was unlikely the disease is spread between humans. “Recent evidence indicates that human to human transmission does not occur, although cases are commonly clustered among families,” he said.
Buruli ulcers can be cured with a combination of antibiotics, however the drugs that aren’t available on the Pharmaceutical Benefits Scheme so are expensive for patients to purchase privately. “These antibiotics have severe side effects in up to one-quarter of patients, and many people also require reparative plastic surgery, sometimes with prolonged hospital admissions,” O’Brien explained.
As a result of the worrying increase in cases, O’Brien and the other authors have called for their questions to be answered urgently. They want to figure out the source of the bacteria and how it is transmitted to humans, and are particularly keen to discover the role mosquitos, possums and other bugs and animals play in the transmission of the disease, as well as environmental factors that determine the growth of it.
They’re also interested in finding out why it is impacting rural Victoria, why it continues to spread to other areas and why confirmed cases are becoming increasingly serious in nature.
“It is only when we are armed with this critical knowledge that we can hope to halt the devastating impact of this disease through the design and implementation of effective public health interventions,” O’Brien and his team said. “The time to act is now, and we advocate for local, regional and national governments to urgently commit to funding the research needed to stop Buruli ulcer.”